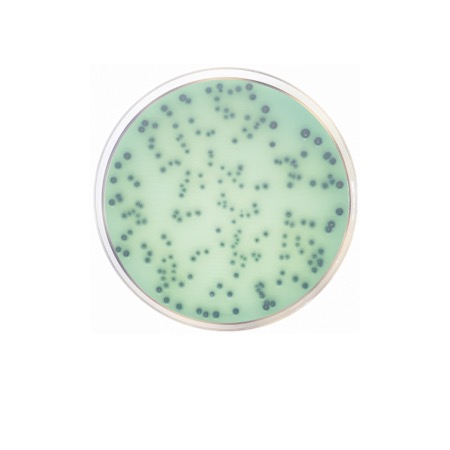

Hektoen Enteric Agar ISO is a dehydrated selective medium designed for the isolation and differentiation of Salmonella and Shigella. The formulation inhibits Gram-positive bacteria and many Gram-negative competitors, while allowing target enteric pathogens to develop characteristic colony morphology. Widely used in food, water and clinical microbiology according to ISO methods.
Hektoen Enteric Agar ISO (catalogue No. 1030) is a dehydrated selective and differential culture medium intended for the isolation and presumptive identification of Salmonella and Shigella species from food, water and clinical specimens. The medium contains peptones as nutrient sources, bile salts to inhibit Gram-positive bacteria, and carbohydrates (lactose, sucrose and salicin) combined with pH indicators for differentiation.
Sodium thiosulfate and ferric ammonium citrate are included to detect hydrogen sulfide (H₂S) production. After incubation, Shigella typically forms green colonies, while Salmonella produces blue-green colonies often with black centers due to H₂S formation. Lactose/sucrose/salicin-fermenting organisms produce orange to salmon-colored colonies.
Advantages
- Selective inhibition of Gram-positive bacteria and many non-target Gram-negative organisms.
- Differential identification based on carbohydrate fermentation and H₂S production.
- Clear and easily interpretable colony morphology.
- Suitable for food, water and clinical microbiology laboratories.
Technical specifications
| Pack size | 500 g |
| Intended use | Selective isolation and differentiation of Salmonella and Shigella spp. |
| Typical colony appearance | Shigella: green colonies; Salmonella: blue-green colonies with black center (H₂S); fermenters: orange/salmon colonies |
| Application industry | Food microbiology, clinical diagnostics, environmental and water testing |
| Storage conditions | 2–25 °C, dry place, tightly closed container |
| Chemical type | Microbial Culture Media |
| Brand | Condalab |
| Pack size | 500 g |